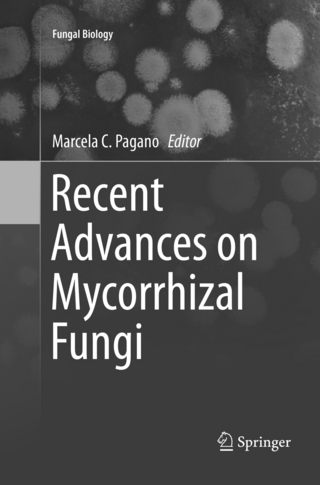
Recent Advances on Mycorrhizal Fungi

From Structure to Function at Multiple Scales
Buch | Hardcover
2018
|
Springer International Publishing
ISBN: 9783319790985
CHF 269,60 (inkl. MwSt)
- Versand in
10-15 Tagen